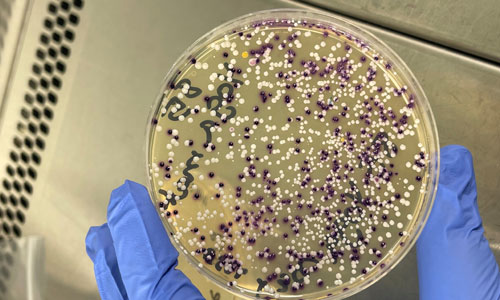
Agar plate with bacteria grown from a yoga mat swab

Reflections on the WAAW @ MDX event

I have been working on AMR research for 20 years in different countries and so initiated an idea and contacted the Society about hosting a week-long event, with elements of outreach, research, educational activities and raising awareness in local community activities.
Who participated?
Together with fellow Champion, Blessing Oyedemi Mbaebie, I was awarded funding to host the WAAW @ MDX event. The event was hosted and supported by Middlesex University, which offered venue, equipment and both admin and technical staff support. The event was held at the main university quad and was well-attended by ~750 attendees throughout the week, including staff, undergraduate and postgraduate students.

Impact and tangible outcomes raising awareness
I set up AMR @ MDX on LinkedIn, X and Instagram and we shared the event’s daily updates via these channels, which included research results, outreach impact news and awareness talks delivered by the esteemed Professor Hemda Garelick and Professor Ajit Shah. Several posts reporting the event's success by the team helped to further disseminate AMR awareness among those of who did not attend the WAAW @ MDX event in person. The event also hosted year 12 students, where a film was shown and a laboratory building tour held. Undergraduate and postgraduate students also had the chance to watch more AMR films and participate in educational prizes sponsored by the Microbiology Society.
Adopting a research approach to raise awareness of AMR
The involvement of the volunteer participants in an ethically approved research activity was quite informative. Several questions were answered regarding resistant pathogens that we encounter in our daily life. The passion of many of our participants to investigate more items superseded our expectations and allowed them to test items that they would not be able to explore otherwise. Interestingly, the results also superseded our ambition and showed the carriage of several antimicrobial resistant bacteria and fungi on jeans, phone cases, yoga mats and even laptops. The lab results were accessible anonymously via social media, allowing the impact of the findings to raise awareness of AMR presence around us, among both participants and more widely.
A swab result from a yoga mat
Reflections and looking ahead
The success of the WAAW @ MDX event was very inspiring and may lead to similar activities and further research activities linked to the project. As a team, we were impressed by the impact of the event, which was measured in social media and in-person activity. Our stand received many questions throughout the week and we helped clarify many misconceptions regarding antibiotics and resistance. Our attendees were equipped with knowledge and the event even stimulated many of the students to pursue a microbiology degree and/or AMR research. The event delivered on stated promises and strengthened the belief that together we can knock out AMR.

All of the blogs in this series are listed together via our WAAW 2024 blog listings and you can also find out more about the Society's AMR work via our Knocking Our AMR webpages.
